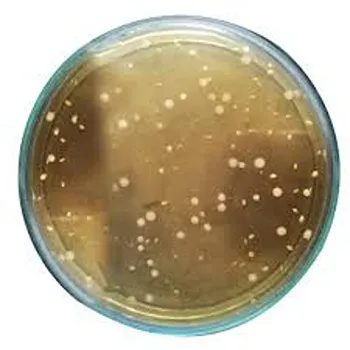

About DEMEGA FORMULATIONS AND EXPORTS
Our organizations trained and experienced team of professionals oversees the sourcing process. The members of our team are familiar with global medical standards. We are able to continue providing top-notch services and goods on a national and worldwide level thanks to their unwavering support.
Company Profile
-
Owner Name
Mr. Sandeep Gajallewar
-
Business Nature
Manufacturers
-
Year Established
2020
-
Annual Turnover
Below Rs. 0.5 Crore Approx.
-
Number of Employees
Below 20
-
GST Number
XXXXFD2357GXXXX
Our Products
Contact DEMEGA FORMULATIONS AND EXPORTS
DEMEGA FORMULATIONS AND EXPORTS
GST- XXXXFD2357GXXXX
Manufacturers
Featured Products
Company Profile
-
Owner Name
Mr. Sandeep Gajallewar
-
Business Nature
Manufacturers
-
Year Established
2020
-
Annual Turnover
Below Rs. 0.5 Crore Approx.
-
Number of Employees
Below 20
-
GST Number
XXXXFD2357GXXXX
DEMEGA FORMULATIONS AND EXPORTS
GST- XXXXFD2357GXXXX
Manufacturers
Contact DEMEGA FORMULATIONS AND EXPORTS
DEMEGA FORMULATIONS AND EXPORTS
GST- XXXXFD2357GXXXX
Manufacturers